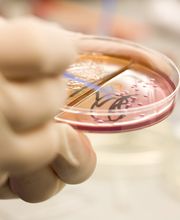
Urologische Gemeinschaftspraxis Dr. Momeni , Dr. Jaeger, Dr. Strasser Urologie, Andrologie und Medikamentöse Tumortherapie Bild 9

Urologische Gemeinschaftspraxis Dr. Momeni , Dr. Jaeger, Dr. Strasser Urologie, Andrologie und Medikamentöse Tumortherapie
+499115209900 (Telefon)
+4991152099020 (Fax)
Info
Praxis für Urologie, Andrologie und medikamentöse Tumortherapie in Nürnberg Wir freuen uns, dass Sie den Weg zu unserer überörtlichen Gemeinschaftspraxis Dres. Kian Momeni, Andreas Jaeger und Hans Strasser gefunden haben. Unsere Fachärzte sind auf Urologie, Andrologie und medikamentöse Tumortherapie spezialisiert. Gründe zu uns zu kommen, gibt es viele. Vielleicht leiden Sie unter Inkontinenz oder Prostatabeschwerden. Vielleicht haben Sie Potenzstörungen und einen unerfüllten Kinderwunsch. Oder Sie tragen sich mit dem Gedanken, sich sterilisieren zu lassen. Solche Themen sind es, mit denen wir Urologen uns täglich beschäftigen. Bei uns finden Sie den Arzt und Urologen Ihres Vertrauens Ein Schwerpunkt unserer Arztpraxis liegt auf der Diagnostik und Therapie von Krebspatienten - übrigens sowohl von Männern als auch von Frauen. Unser Team besteht aus drei Ärzten und einer Ärztin sowie engagierten Fachangestellten. Gemeinsam begleiten Sie mit fachlicher Kompetenz, viel Empathie und Fürsorge. Notwendige Operationen können wir teilweise ambulant bei uns in der Praxis durchführen, bei stationären Behandlungen arbeiten wir mit dem Klinikum Nürnberg zusammen. Und vorbeugend erhalten Sie bei uns Vorsorgeuntersuchungen, z.B. zur Früherkennung von Darmkrebs.
Öffnungszeiten
- Montag
- 08:00 bis 12:00 - 14:00 bis 18:00
- Dienstag
- 08:00 bis 12:00 - 14:00 bis 18:00
- Mittwoch
- 08:00 bis 12:00 - 13:00 bis 18:00
- Donnerstag
- 08:00 bis 12:00 - 14:00 bis 18:00
- Freitag
- 08:00 bis 12:00
- Samstag
- Geschlossen
- Sonntag
- Geschlossen
Medien

Map
Am Stadtpark 2, 90409 Nürnberg


